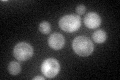
YLR438W
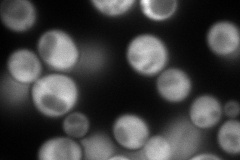
YLR438W
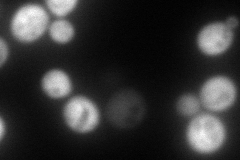
YLR438W
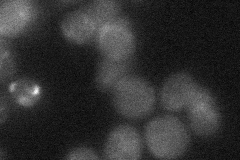
YLR438W
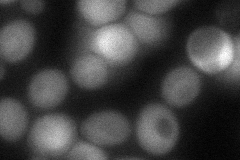
YLR438W
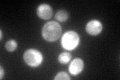
YLR438W

View description
L-ornithine transaminase (OTAse), catalyzes the second step of arginine degradation, expression is dually-regulated by allophanate induction and a specific arginine induction process; not nitrogen catabolite repression sensitive
Localization:
Intensity:
Fold change:
Significance:
-
C’ GFP library in SD
nucleus:cytosol62.49 -
N' NOP1pr-GFP in SD
cytosol274.204 -
N' TEF2pr-mCherry in SD
cytosol252.686 -
N' NATIVEpr-GFP in SD
below threshold19.441 -
N' TEF2pr-VC and Cyto-VN in SD
cytosol73.2727 -
C’ GFP library in SD+DTT

nucleus.cytosol64.381.03No -
C’ GFP library in SD+H2O2

nucleusN/AN/ANo -
C’ GFP library in Starvation Media
nucleusN/AN/AYes -
C’ GFP library on the background of Pup2-DaMP

nucleus:cytosol -
C’ GFP library on the background of CCT mutant

nucleus:cytosol62.2670.996263No
